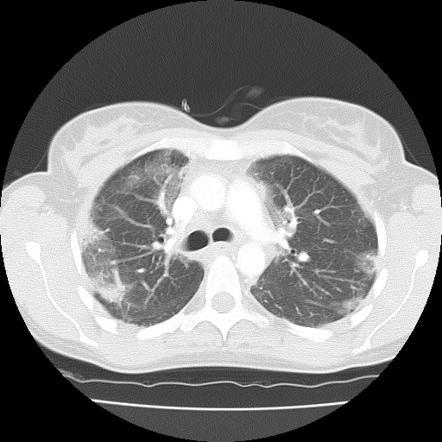
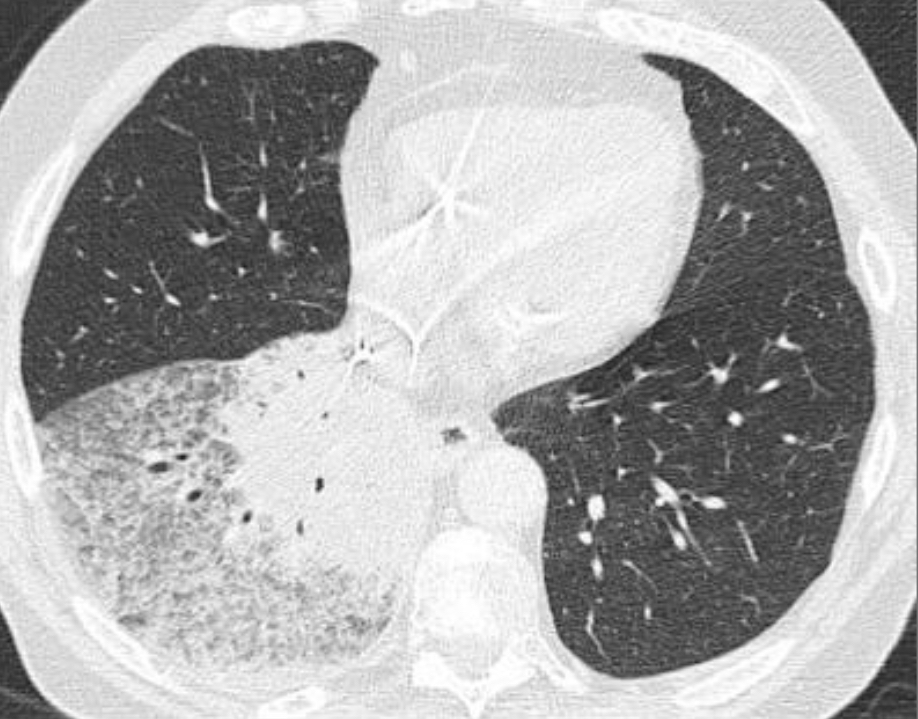

Stacked cystic spaces/honeycombing, lower lobe predominant, subpleural reticulation, architectural distortion, and volume loss

UIP Pattern–
a/w connective tissue disorders (esp RA but can be seen in others//)
IF no clinical cause, then it’s IPF
Ground glass opacities + fibrosis, lower lobe predominant, peripheral, fine reticulation. NO honeycombing
usu w/subpleural sparing, more symmetric

NSIP Pattern
Fibrotic type and cellular type, fibrotic more common
a/w CTD–esp dermatomyositis/polymyositis, sjogrens, SLE
anti-synthetase, RA, etc
Drug reactions esp chemo
Castleman disease
NOT associated with smoking
Upper lobe predominant centrilobular ground glass, OR prominent mosaic pattern

Hypersensitivity Pneumonitis
(subacute)
chronic peribronchiolar inflammation w/poorly defined granulomas and giant cells in the interstitium or alveoli on pathology.
these resolved without antibiotics

Hypersensitivity pneumonitis
lobular GGO
Need constellation of findings to dx: exposure to an offending antigen, characteristic signs and symptoms, abnormal chest findings on physical examination, and abnormalities on pulmonary function tests and imaging
describe, and dx

chronic hypersensitivity pneumonitis
Mosaic pattern with areas of ground-glass atenuation and areas of low attenuation.
Fibrosis and parenchymal distortion in a mid zone distribution.
left vs right?

Left UIP w honeycombing
Right Chronic HP
Ground Glass and Fibrosis
Ddx
GGO with fibrosis, and cystic changes, irregular linear opacities

DIP
classically described as triangular-shaped regions of increased density radiating from the hilar regions to the periphery; although seen in a minority
COP
Multifocal peripheral GGO and consolidations (subpleural/peribronchial)
–when there is no underlying cause identified,
otherwise it’s 2* OP

Lymphangioleiomyomatosis (LAM)

Large thin-walled cysts diffusely distributed in the lungs that will eventually replace the entire lung parenchyma.
exclusive to women of child-bearing age, except for TS associated in men
–lymphangiomas and AMLs are commonly associated.
–A/w chylothorax

Empyema necessitans
chronic empyema attempting to decompress through the chest wall.
Common organisms include Tuberculosis, Actinomycosis, Staphylococcus, Aspergillosis, Mucormycosis, and Blastomycosis.
Look for loculated pleural fluid or mass with rib destruction.
Diagnosis = fine needle aspiration biopsy and microbiology.
Treatment = surgical drainage and antibiotics.
“BATMAN”
In a patient w/remote hx of blunt chest trauma and no spleen

Splenosis
autotransplantation of splenic tissue following traumatic or surgical disruption of the spleen.
Look for multiple pleural masses in the left hemithorax in a patient with a history of remote trauma.
Tc-99m sulfur colloid is often used to diagnose (uptake in splenic tissue, specifically reticuloendothelial tissue).
63M with chronic cough
Lung Adenocarcinoma
mixed ground-glass and solid consolidation –> “cancers that look like PNA”
-> lymphoma also looks like PNA
43yo F with SLE presents with dyspnea

Pericardial Effusion
cardiac shadow is enlarged but the pulmonary vessels are not dilated –> suspect a pericardial effusion.
azygous vein and SVC may be dilated, reflecting the elevated central venous pressure necessary to maintain right ventricular filling.
mediastinal interface over the left hilum in the absence of enlargement of the pulmonary arteries should also alert you to possibility of a pericardial effusion (fluid accumulating in a pericardial recess) because an enlarged cardiac chamber, such as the left atrial appendage, will not produce an interface this high along the left cardiac border.
Asymptomatic pt with persistent opacity on CXR

Broncholith
should always be considered as a potential etiology when calcified intrapulmonary lymph nodes are present, particularly when they are located in the involved bronchopulmonary segment.
—Other things that can happen in bronchi:
—> soft tissue endobronchial lesion could be carcinoid
—> diffuse or segmental bronchial wall thickening could be seen in GPA/Wegener’s
Post-op. What are these wires?

From a sternotomy:
from a broad transverse incision across the anterior chest wall and the sternum and (typically) along the anterior 4th intercostal spaces = a redo “clamshell” sternotomy.
Elderly lady w/RUL PNA—> what is the most likely causative organism?

actinomycosis
mass-like right upper lobe consolidation with a parapneumonic pleural effusion. Bone window w/permeative destruction of adjacent skeletal structures.
49 year old woman with a rash on her face. CT chest with multiple thin walled cysts

LAM
a/w renal AMLs and LAD, seen here
Almost exclusively middle aged women although can also occur in TS
p/w exertional dyspnea, recurrent PTX is common
Newly developed

Aspiration PNA
Atalectasis in both LL but also new consolidation and fluid in the bronchi (higher up also see fluid in the esophagus)
hypoplastic right lung with ipsilateral mediastinal shift and vertical vein (PAPVR of a portion or all of the right lung)

Scimitar Syndrome

Could also px as: bilobed right lung with a hyparterial right main and upper lobe bronchus
If systemic arteries from the abdomen are found to supply a portion of the lung, the resultant “complete” entity is also known as the scimitar syndrome.
**hyparterial bronchus–bronchus is below the PA (normal on the L but not the R)
Most likely diagnosis?

Neurofibromatosis
most common thoracic manifestations include neurofibromas in the subcutaneous tissues and mediastinum. In this case, innumerable neurofibromas are present in the axillae , chest wall , and mediastinum . Although not present in this case, other regions of the chest, including the lungs and osseous structures such as the spine and ribs, may be affected.
50M w/40 year smoking hx

RB-ILD
upper lung zone predominant process that features patchy ground-glass opacities and faint centrolobular nodules, as seen in this case. On a spectrum with DIP. Can see RB-ILD within 2 years of starting smoking, and treatment is cessation.
LCH—> Langerhans cell granulomatosis is seen almost exclusively in smokers. Imaging features of Langerhans cell granulomatosis include centrilobular nodules that eventually evolve into bizarre-shaped cysts and resultant paracicatricial emphysema
Incidental finding in asx. pt

Bronchial Atresia
the combination of a blind-ending tubular opacity and a hyperinflated/hypovascular left upper lobe is typical of bronchial atresia.—> mucocele is also typical.
LUL, particularly apico-posterior segment MC location
Congenital lobar hyperinflation usu presents in neonatal period w/respiratory distress
Both AVM and intralobar sequestration would have more prominent vessels
large extrapulmonary/soft tissue mass in an adolescent or young adult, may involve ribs/chest wall

Askin tumor

form of primitive neuroectodermal tumor (PNET).
arises in the soft tissues of the thorax. Children and young adults, present with chest wall pain. Radiographs show a heterogeneous mass with or without rib destruction. Rib destruction is less common than in Ewing sarcoma. An Askin tumor may or may not have a pleural effusion. Lung and bone mets are common.
–> Ewings would be lytic lesion with cortical destruction